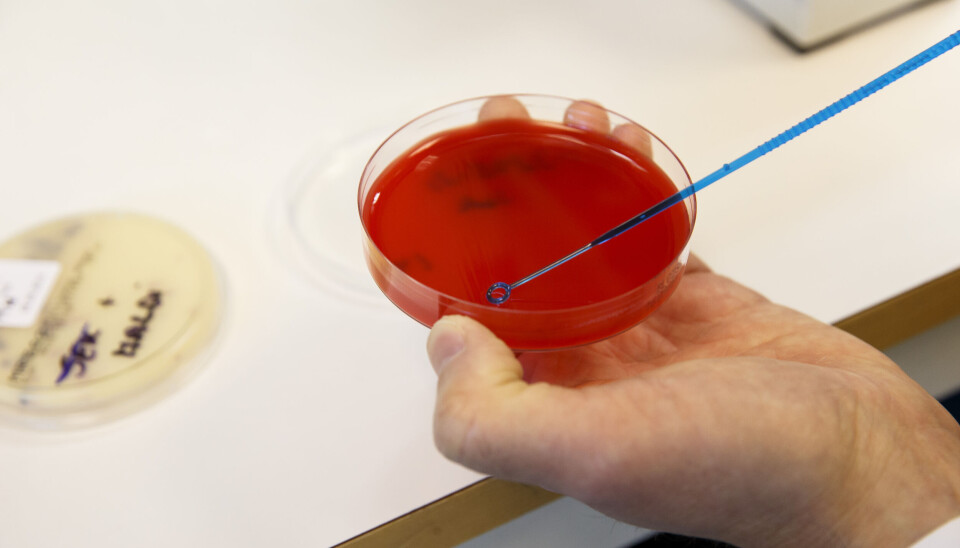

Folkehelseinstituttet: Økt resistens mot antibiotika hos enkelte bakterier
Til tross for en markant nedgang i bruk av antibiotika de siste elleve årene, øker resistensen hos enkelte bakterier markant, ifølge Folkehelseinstituttet.
Siden 2012 har det vært en reduksjon på 23 prosent i antibiotikabruk. Forbruket er nå tilbake til noenlunde samme nivå som før pandemien, ifølge FHIs årsrapport om forekomst av antibiotikaresistens og forbruk av antibiotika til mennesker i 2023.
– Men til tross for nedgang i antibiotikabruk, viser undersøkelser en markant økning av antibiotikaresistens for enkelte bakterier, som vi ikke ønsker at skal etablere seg i norsk helsetjeneste, sier leder Gunnar Skov Simonsen for Norsk overvåkingssystem for antibiotikaresistens hos mikrober. Han er tilknyttet Universitetssykehuset i Nord-Norge og FHI.
Simonsen knytter økningen til økt reisevirksomhet til land med høy forekomst av resistens.
– Det er viktig å styrke smittevernet i helsetjenesten for å hindre at resistente bakterier, virus og sopp etablerer seg der, samt å jobbe internasjonalt mot antibiotikaresistens for å opprettholde den relativt lave forekomsten av resistens som vi har i Norge i dag, sier han.
Resultatene som presenteres i rapporten, viser at strategiene mot antibiotikaresistens har vært vellykkede både i husdyrholdet og i helsevesenet.